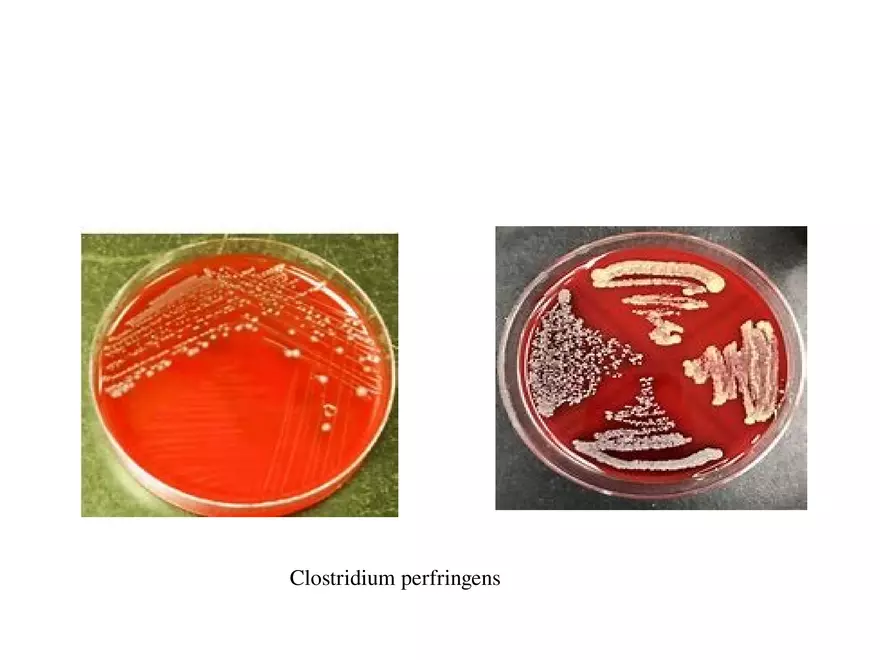
Clostridium Perfringens BTY618 - Page 34

Lecture Note
Clostridium Perfringens BTY618
-
University:
University of South Florida -
Course:
MCB 3020 | General Microbiology Academic year:
2021
-
Views:
463
Pages:
37
Author:
ilikemyicons0y5
Related Documents
- Caring - The Art and Science of Caring and Communication
- Azygos Vein - Lecture Note
- Difference Between Cervical , Thoracic, and Lumbar Vertebrae
- Diaphragm (Thoraco Abdominal)
- Coronary Sinus Lecture Note
- Cavernous Sinus - Study Note
- Carpal Tunnel Notes
- Carotid Triangle
- Bones Anatomy - Complete Study Notes
- Bones & Skeletal Tissue - Big Lecture Note
- Anastomosis of Axillary Artery
- Axillary Artery - Notes
- Axillary (Circumflex) Nerve - Study Notes
- Axilla - Complete Lecture Notes
- Atypicalpical Intercostal Nerves
- Arch of Aorta - Exam Prep Notes
- Anatomy of Peritoneum
- Anatomy of Bones - Hand Sketches
- Anatomy - Complete Study Notes
- Anatomical Positions of Some Important Bones
Report
Tell us what’s wrong with it:
Thanks, got it!
We will moderate it soon!
Report
Tell us what’s wrong with it:
Free up your schedule!
Our EduBirdie Experts Are Here for You 24/7! Just fill out a form and let us know how we can assist you.
Take 5 seconds to unlock
Enter your email below and get instant access to your document